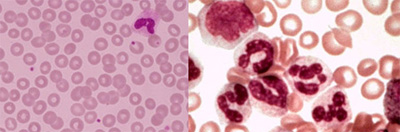
Blutbild links normal rechts CML

Chronische myeloische Leukämie (CML) - Wirksame Medikamente zur Behandlung

Medikamente
Für die genaue Diagnostik und Festlegung, respektive Überwachung der Therapie wird der Hausarzt einen Krebsspezialisten (Onkologen) beiziehen. Die gute Zusammenarbeit zwischen Patient, Hausarzt und dem Spezialisten ist Grundvoraussetzung für eine erfolgreiche Behandlung.
Folgende Therapie-Themen sollen etwas näher beleuchtet werden:
- Therapie mit Medikamenten
- Therapieziele
- Therapieansprechen – Meilensteine bei der TKI-Behandlung
- Nebenwirkungen
- Stammzelltransplantation
- Komplementärmedizin
- Kinderwunsch
- Checkliste für Gespräch mit dem behandelnden Arzt
Therapie mit Medikamenten
Dank wirksamer Medikamente ist es heute möglich, die Erkrankung CML über viele Jahre hinweg in Schach zu halten und damit eine weitgehend normale Lebenserwartung mit guter Lebensqualität für Betroffene zu bewahren. Dies ist für die meisten Patienten das wichtigste Ziel der Behandlung. Von Bedeutung ist dahingehend ein früher Behandlungsbeginn mit einem möglichst optimalem und raschen Ansprechen auf die Therapie. In den Behandlungsrichtlinien wird ein optimales Ansprechen (siehe auch Therapieansprechen) auf die Therapie wie folgt definiert:
- Nach 3 Monaten ein komplettes hämatologisches Ansprechen (Normalisierung des Blutbildes)
- Nach 12 Monaten ein komplettes zytogenetisches Ansprechen (kein Philadelphia-Chromosom mehr nachweisbar)
- Nach 18 Monaten ein sehr gutes molekulargenetisches Ansprechen (weniger als 0.1% der Zellen enthalten die BCR-ABL-Genveränderung)
Grundsätzlich wird bei der Behandlung einer Krankheit zwischen Erst- und Zweitlinientherapien unterschieden. Erstlinientherapien kommen bei neu diagnostizierter Krankheit zum Einsatz, Zweitlinientherapien erst dann, wenn die Erstlinientherapien nicht oder nicht mehr genügend wirken, respektive wenn die Erstlinientherapie versagt.
Bis vor einigen Jahren wurde die CML vor allem mit Interferonen, einer ursprünglich körpereigenen Substanz, sowie mit Chemotherapien behandelt. Später kamen sogenannte Tyrosinkinasehemmer zu den Behandlungsmöglichkeiten hinzu. Diese Medikamentenklasse hemmt die Vermehrung der Leukämiezellen und kann damit an der Ursache der CML ansetzen.
In der Schweiz sind inzwischen drei Tyrosinkinasehemmer auf dem Markt, welche zur Erstlinientherapie zugelassen sind.
Therapieziele
Im Verlauf der Behandlung wird im Blut und auch im Knochenmark regelmässig in bestimmten Abständen kontrolliert, wie sich die Therapie auf die Vermehrung der Leukämie-Zellen und die Qualität der Blutbildung auswirkt. Das Ziel jeder Therapie ist nicht nur die Beseitigung der leukämischen Zellen im Blut, sondern auch das Verschwinden der Philadelphia-Chromosoms sowie der BCR-ABL-Genveränderung in möglichst allen Zellen.
Um die CML-Erkrankung völlig zurückzudrängen, müssen daher folgende drei aufeinanderfolgende Therapieziele erreicht werden:
1. Komplettes hämatologisches Ansprechen: Normalisierung des Blutbildes
Im Blut wird beurteilt, wie gut die Behandlung das Blutbild, d.h. die Bildung der weissen und roten Blutkörperchen sowie der Blutplättchen beeinflusst. Die Normalwerte im Blut sind in folgender Tabelle zusammengefasst:
|
Zu bestimmen |
Normalwert |
|---|---|
| Rote Blutkörperchen (Erythrozyten) | Frau: 3.5-5 Millionen pro µl (Mikroliter) Mann: 4.3-5.9 Millionen pro µl |
| Hämoglobin (roter Blutfarbstoff) | Frau: 120-150 g/l Mann: 130-170 g/l |
| Leukozyten (weisse Blutkörperchen) | 3200-9800 pro µl, wobei 60-80% Granulozyten |
| Thrombozyten (Blutplättchen) | 130'000-400'000 pro µl |
Im chronischen Stadium der CML sind vor allem die Leukozyten um ein Vielfaches erhöht, allenfalls findet sich auch eine geringere Erhöhung der Blutplättchen. Der Therapieeffekt kann also im Blutbild vor allem anhand des Rückgangs der Leukozyten gemessen werden. Von einem kompletten hämatologischen Ansprechen spricht man dann, wenn sich das Blutbild unter der Therapie normalisiert (Leukozyten < 10'000 und Blutplättchen < 450'000 pro µl). Kann lediglich eine Besserung des Blutbildes, aber keine Normalisierung festgestellt werden, spricht man von einem partiellen Ansprechen.
Unter der Therapie kann es zu einem starken Abfalls der Blutplättchen kommen. In solchen Fällen ist es manchmal notwendig, die Therapie kurzzeitig zu unterbrechen oder die Dosierung anzupassen.
2. Komplettes zytogenetisches Ansprechen: Im Knochenmark sind keine Leukämiezellen (Leukozyten mit Philadelphia-Chromosom) mehr nachweisbar
In der Untersuchung des Knochenmarks wird beurteilt, wie stark die Behandlung das Philadelphia-Chromosoms in den weissen Blutzellen zum Verschwinden bringt. Werden keine Zellen mit dem Philadelphia-Chromosom gefunden, spricht man von einem kompletten zytogenetischen Therapieansprechen. Auch hier gibt es ein partielles (teilweises) Ansprechen, wenn dieses Ziel noch nicht ganz erreicht wurde.
3. Gutes molekulares Ansprechen: Der BCR-ABL-Wert ist im Blut auf einen minimalen Wert abgesunken
Im Blut können durch die äusserst sensible Untersuchung PCR auch kleinste Restmengen an Zellen mit dem BCR-ABL-Gen nachgewiesen werden. Die Methode ist so genau, dass ein einziges BCR-ABL-Gen auch unter einer Million normalen Zellen identifiziert wird. Von einem guten (major molecular Response=MMR) molekulargenetischen Ansprechen spricht man, wenn in zwei aufeinanderfolgenden PCR -Tests der BCR-ABL unter 0.1% gesunken ist. Ist dieses Ziel durch die Therapie erreicht, kann von einer guten Prognose und einer grossen Chance für ein langes krankheitsfreies Leben ausgegangen werden.

Das untersuchende Labor sollte gemäss Empfehlungen von Experten über eine Zertifizierung verfügen, welche attestiert, dass die PCR-Ergebnisse nach dem Internationalen Standard ausgegeben werden.
Für die Behandlung der CML wurde von den CML-Experten des Europäischen Leukämie Netzwerkes (ELN) ein Ablaufplan entwickelt, der vorgibt, in welchen Abständen die hämatologischen, zytogenetischen und molekularen Tests durchgeführt werden sollen und welche Zielkriterien (sogenannte "Meilensteine") dabei zu erreichen sind. Denn mit der Verfügbarkeit von mittlerweile drei Tyrosinkinasehemmer zur Erstlinientherapie besteht die Möglichkeit, auf eine alternative Substanz auszuweichen, wenn diese Meilensteine nicht problemlos erreicht werden.
Zu welchen Zeitpunkten erfolgen die verschiedenen Tests:
Die hämatologischen Tests werden alle 2 Wochen bis zum Erreichen des kompletten hämatologischen Ansprechens durchgeführt. Die zytogenetischen und molekularen Tests erfolgen 3, 6 und 12 Monate nach Therapiebeginn. Nach Erreichen eines guten molekularen Ansprechens erfolgt alle 3 bis 6 Monate ein molekularer Test zur BCR-ABL-Bestimmung.
Therapieansprechen - Meilensteine bei der TKI-Behandlung
Das Erreichen der Meilensteine zeigt an, dass der Patient optimal auf die TKI-Behandlung anspricht und damit die besten Aussichten auf ein langes krankheitsfreies Leben und eine normale Lebenserwartung hat. Dabei ist vor allem ein frühes und tiefes molekulares Ansprechen entscheidend. Die Tiefe des Ansprechens zeigt der BCR-ABL-Wert an, der mittels PCR-Technik (Polymerasekettenreaktion) aus einer Blutprobe gemessen wird.
Patienten können sehr unterschiedlich auf die Behandlung ansprechen, sodass es durchaus möglich ist, dass ein Meilenstein nicht immer zum geplanten Zeitpunkt erreicht wird. Die Behandlung kann aber trotzdem wirksam sein. Wird ein Meilenstein also knapp verfehlt, heisst das vorerst nur, dass die Behandlung enger überwacht werden muss.
Folgende Meilensteine gilt es zu erreichen:
- Hämatologischer Meilenstein (Blutbild): Nach 3 Monaten soll ein komplettes hämatologisches Ansprechen erreicht sein.
- Zytogenetische Meilensteine (Philadelphiachromosom): Idealerweise wird ein komplettes zytogenetisches Ansprechen nach 6 Monaten erreicht.
- Molekulare Meilensteine (BCR-ABL-Wert): Als optimales molekulares Ansprechen gilt, wenn der BCR-ABL-Wert nach 3 Monaten die 10%-Marke und nach 12 Monaten die 0.1%-Marke erreicht hat. Das Erreichen der 0.1%-Marke wird als "gutes molekulares Ansprechen oder kurz MMR (engl.: Major Molecular Response) bezeichnet und stellt den wichtigsten molekularen Meilenstein dar.
Manche Patienten sprechen sogar noch tiefer an, das heisst, sie erreichen noch tiefere BCR-ABL-Werte, z.B. MR4 (0,01%-Marke), MR4.5 (0,0032%-Marke) oder sogar MR5 (0.001%-Marke). In klinischen Studien wird untersucht, ob bei Patienten mit einem tiefen BCR-ABL (mindestens MR4 oder MR4.5) die Therapie ganz abgesetzt werden kann. Die Studien weisen darauf hin, dass über 50% dieser Patienten ohne Therapie krankheitsfrei bleiben. Die Medizin spricht von Therapiefreier Remission (TFR).

Nebenwirkungen
Jedes wirkungsvolle Medikament kann auch Nebenwirkungen haben. Obwohl die Tyrosinkinasehemmer im Allgemeinen gut - und im Vergleich zu früheren Therapien sogar besser - vertragen werden, können unerwünschte Effekte auftreten. Die meisten Nebenwirkungen sind jedoch mild und können mit einfachen Massnahmen behandelt werden. Wichtig ist, dass beim Auftreten von Nebenwirkungen der behandelnde Arzt rasch informiert wird. Achtung: Die Therapie darf nicht selbständig unterbrochen werden, da sonst der Nutzen eingeschränkt werden kann.
Mögliche Nebenwirkungen sind:
- Magen-Darm-Beschwerden wie Übelkeit oder Durchfall
- Ödeme (Wassereinlagerung ins Gewebe)
- Müdigkeit, Kopfschmerzen
- Muskelkrämpfe
- Hautausschläge, Juckreiz
- Abnahme der Konzentration von roten Blutkörperchen, weissen Blutkörperchen oder Blutplättchen im Blut
Was im Einzelfall unternommen werden kann, muss mit dem behandelnden Arzt besprochen werden; er hat zusammen mit dem Patienten den besten Überblick über die Erkrankung. Was der Patient zur Linderung von Nebenwirkungen selber tun kann, lesen Sie im Kapitel: "Leben mit CML"
Stammzelltransplantation
Eine Stammzelltransplantation kommt grundsätzlich in zwei Situationen in Frage: Bei jungen Patienten oder wenn die medikamentösen Therapien nicht angeschlagen haben. Die Transplantation kann zur Heilung der CML führen. Es besteht aber ein beträchtliches Risiko, während der Therapie ernsthaft zu erkranken oder zu sterben. Dies ist der Grund, warum von den meisten Betroffenen zunächst eine medikamentöse Therapie bevorzugt wird.
Grundsätzlich ist die Transplantation in jeder Phase der CML möglich, die Komplikationsrate und damit die Sterblichkeit steigen aber, wenn die Transplantation in der Akzelerationsphase oder Blastenkrise erfolgt.
Bei der allogenen Stammzelltransplantation werden Stammzellen von einem Spender mit möglichst guter genetischer Übereinstimmung (HLA-Merkmale) auf den Empfänger übertragen.
Vor der Transplantation müssen die eigenen, kranken Stammzellen mit einer hoch dosierten Chemotherapie vernichtet werden. Während dieser Phase - bis einige Wochen nach Transplantation - besteht ein erhebliches Risiko für Infektionen, da das Immunsystem stark geschwächt ist. Zudem muss immer mit einer Abstossungsreaktion gerechnet werden, insbesondere wenn die genetischen Strukturen zwischen Spender und Empfänger nicht ideal übereinstimmen. Diese Abstossungsreaktionen können mit Medikamenten zwar meistens unter Kontrolle gehalten werden, die Lebensqualität ist dann aber häufig beträchtlich eingeschränkt und diese Therapie kann ihrerseits zu Organschädigungen führen.
Komplementärmedizin
Es ist verständlich, dass sich Menschen mit chronischen Erkrankungen danach sehnen, neben der klassischen, meist als streng empfundenen Krebstherapie auch alternative Massnahmen zu prüfen. Zusatzbehandlung sollten aber immer erst mit dem behandelnden Onkologen besprochen werden, da auch zwischen so genannten "natürlichen" Produkten und Krebsmedikamenten Wechselwirkungen auftreten können. Unter Umständen können diese den Nutzen der Therapie gefährden. Wichtig: Bedürfnisse mit dem Arzt besprechen, auch wenn die Angst besteht, auf Unverständnis zu stossen.
Kinderwunsch
Sind jüngere Menschen von der Erkrankung betroffen, kommt zur Behandlung der Krankheit noch etwas Wichtiges hinzu: die Familienplanung. Während einer medikamentösen Therapie – die Monate dauern kann – ist eine konsequente Verhütung zwingend. Die Medikamente können ein heranwachsendes Kind im Mutterleib erheblich schädigen.
Bei Kinderwunsch gibt es die Möglichkeit, vor der Therapie Spermien oder Eizellen zu konservieren.
Ist eine Frau zur Zeit der Diagnose schwanger, kompliziert das die Therapie und ein erfahrenes Zentrum muss die Behandlung leiten.
Neuere Studien zeigen, dass bei einem sehr guten Ansprechen der Behandlung mit Erreichung eines BCR-ABL Wertes von langfristig unter 0.01% die Therapie abgesetzt oder zumindest für eine Zeit unterbrochen werden kann. Dies ermöglicht neue Perspektiven für eine Schwangerschaft bei CML Erkrankung.
Checkliste für das Gespräch mit dem behandelnden Arzt
So sind Sie über alle wichtigen Punkte rund um Ihre Erkrankung optimal informiert